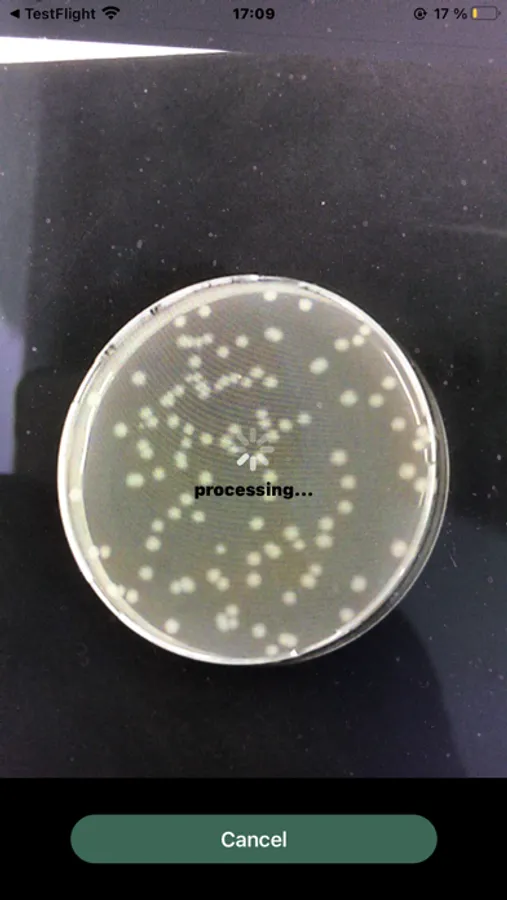
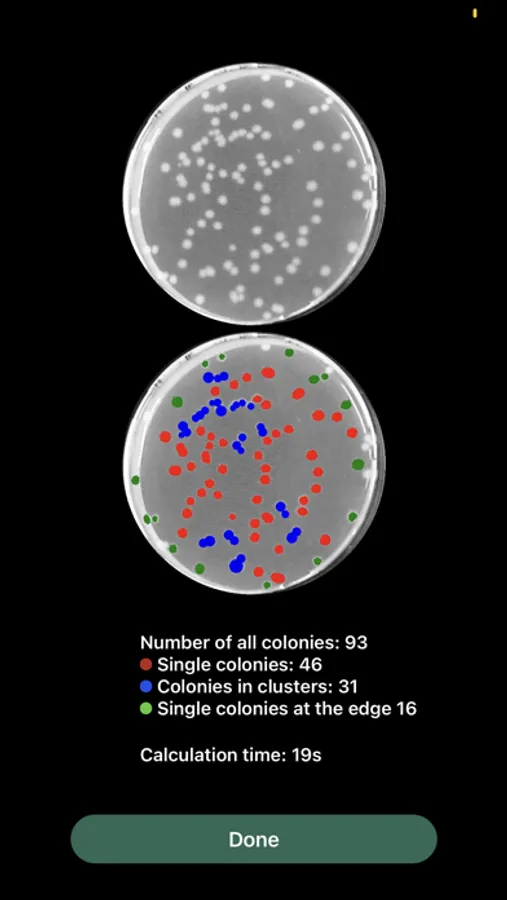

About Colony-Counter
The Colony Counter App is a tool, which allows taking and scanning pictures of bacterial colonies, by the inbuilt camera of the smartphone or tablet. Thanks to an image-processing algorithm, providing digital picture analysis, the app counts and determines the amount of captured colonies, enabling lab work to be more easy.
Key Features: (to be appended)
- Camera Page: Autofocus is available. Click on the shutter button to take a photo.
- Analysis Page: The user can stop the scanning process by tapping the Cancel button. Then back to the camera page. If analysis successful, the photo will be saved to a specific album on the device (e.g., album "Colony Counter").
- Result Page: Display Number of all colonies, Single colonies, Colonies in clusters, Single colonies at the edge, and Calculation time.
Note: The original image-processing algorithm has been developed by the Institute of Technical Chemistry (TCI) of the Leibniz University Hannover. MPDL is operating the app.
Key Features: (to be appended)
- Camera Page: Autofocus is available. Click on the shutter button to take a photo.
- Analysis Page: The user can stop the scanning process by tapping the Cancel button. Then back to the camera page. If analysis successful, the photo will be saved to a specific album on the device (e.g., album "Colony Counter").
- Result Page: Display Number of all colonies, Single colonies, Colonies in clusters, Single colonies at the edge, and Calculation time.
Note: The original image-processing algorithm has been developed by the Institute of Technical Chemistry (TCI) of the Leibniz University Hannover. MPDL is operating the app.
Colony-Counter Screenshots
Tap to Rate: